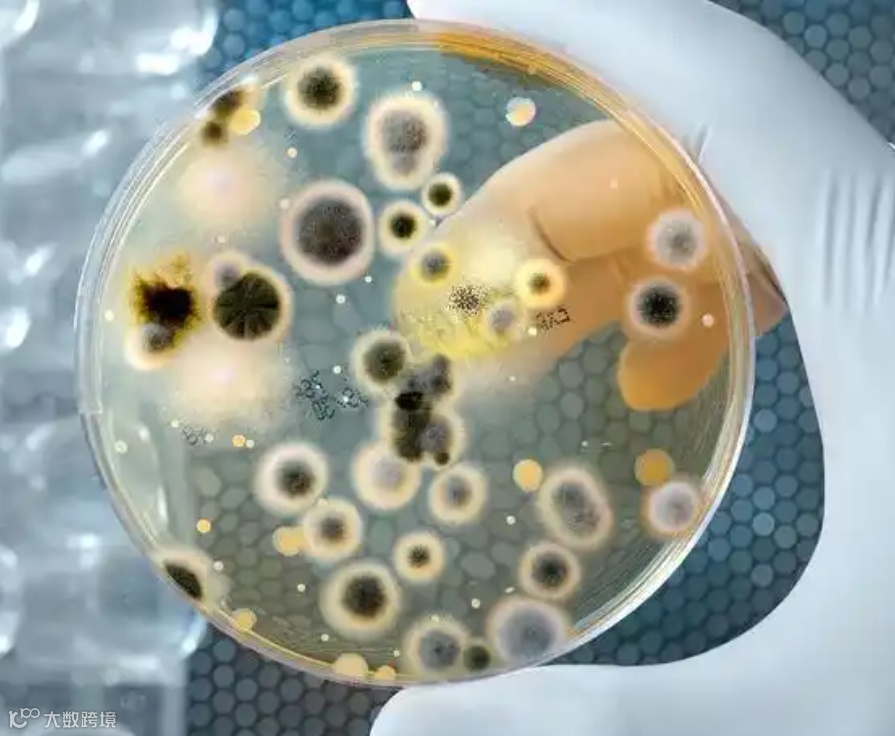

在西方文化中,百里香享有极高的地位。这种带有强烈香气的植物,早在公元前3000多年便被古埃及人用作防腐剂,而在古希腊医学之父希波克拉底的药单中,也占据了一席之地。
《本草纲目》中记载,百里香有祛风解表、行气止痛的功效,用于治疗感冒、牙痛、消化不良、急性胃肠炎、高血压等疾病。

罗马人传说,出征前佩戴百里香能激发勇气,因此罗马军人的披肩上常绣有百里香图案。百里香在当时还以其驱毒虫、解蛇毒的功效闻名。
中世纪瘟疫肆虐欧洲,百里香被用于治疗疫病和麻风病。后来,欧洲人在法院和审判庭等公共场所喷洒百里香水,以净化空气。

百里香原产于西欧至南欧的植物,广泛用于烹饪、漱口、百花香和芳香疗法。由于其丰富的精油成分,百里香油具有多种健康益处,包括防腐、抗菌、解痉、降压和镇静作用,这些功效在地中海地区已被认可数千年。
百里香整株具有芳香的气味,自古以来就被用作香料蔬菜和蜜源植物,是人类长期以来应用的天然调味香料之一。中国早在元朝就有用百里香作调味香料的记载。在烹调海鲜、肉类、鱼类等食品时,加入少许百里香粉可以去除腥味,增加菜肴的风味;在腌菜和泡菜中加入百里香,能提升其清香和草香味。
1970年,国际标准化组织(ISO)正式确认百里香可用作食物香辛料。研究表明,百里香的营养成分远高于普通蔬菜,富含碳水化合物、蛋白质、维生素C、硒、铁、钙和锌,尤其是含有大量单萜等挥发性成分,对人体具有极高的食用营养价值。百里香蜂蜜浓度高,香气浓郁,呈浅琥珀色,其中氨基酸含量丰富,对人体大有益处。

百里香能够保护皮肤免受有害细菌和真菌感染,是治疗痤疮、伤口、疤痕和烧伤的理想家庭药物,也可用于治疗皮疹。例如,湿疹是一种常见的皮肤疾病,表现为干燥、红痒的皮肤,有时伴有水疱或破裂。
湿疹的常见原因包括消化不良、应激、遗传、药物和免疫缺陷。百里香通过促进消化、排尿排毒、放松心情和发挥抗氧化作用,成为治疗湿疹的完美天然选择。
发表在《英国营养学杂志》上的一项研究显示,百里香具有显著的抗氧化酶活性,能够改善衰老大鼠的脑功能和脂肪酸组成。抗氧化剂有助于防止氧气造成的损害,减少癌症、痴呆和心脏病的风险。摄入高抗氧化食物可以延缓衰老过程,带来健康、透亮的肌肤。

百里香植株适应多种环境、气候和土壤,拥有超过300个品种。百里香主要成分包括α-苏云烯、α-蒎烯、莰烯、β-蒎烯、对伞花烃、α-萜烯、芳樟醇、冰片、β-石榴素、百里香酚和香芹酚。精油具有辛辣、浓郁且穿透力强的香气。

百里香酚这种化合物具有多种生物活性,包括抗氧化、抗炎、抗菌和抗真菌作用。其中,百里香酚的抗菌活性尤为引人注目,科研人员通过体外实验和体内实验,证实了其对多种细菌、真菌和病毒具有抑制作用。这使得百里香酚在开发新型抗菌药物、防腐剂等方面具有潜在的应用价值。
此外,百里香酚还具有较强的抗氧化能力,能够清除自由基、减轻炎症反应。这一特性使得百里香酚在医药领域具有广泛的应用前景,例如在治疗炎症性疾病、预防心血管疾病等方面。

抗菌活性研究:百里香酚的抗菌活性是其最受关注的特性之一。科研人员正通过深入研究其抗菌机制,对包括金黄色葡萄球菌、大肠杆菌和霉菌等有抑制作用,为开发新型抗菌药物提供新的思路。同时,百里香酚在防腐剂领域的应用也备受关注,其天然、安全、有效的特点使得它成为了一种理想的防腐剂替代品。
抗氧化与抗炎作用研究:百里香酚的抗氧化和抗炎作用也为其在医药领域的应用提供了广阔的空间。科研人员正在探索其在治疗炎症性疾病、预防心血管疾病等方面的应用效果。
农业与食品领域的应用:百里香酚作为一种天然防腐剂,在食品和农产品保鲜方面具有广泛的应用。科研人员通过研究百里香酚的抗菌、抗氧化等特性,探索了其在延长食品保质期、提高农产品品质等方面的应用效果。此外,百里香酚还可以作为一种天然的农药替代品,用于防治农作物病虫害,减少化学农药的使用量。
目前,已有大量研究表明,百里香酚具有抗氧化、抑菌消炎、提高免疫力、防腐等作用,具有药用价值,用于口腔卫生品中,同时还可作为防腐剂、医用杀菌剂。此外,百里香酚作为抗氧化剂用于氮化钛的特殊试剂。
圣菲环保



